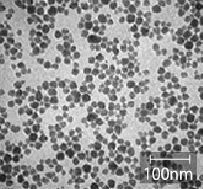

有机硅溶胶是指在有机溶剂中稳定分散的纳米级硅胶液体。
以前的亲水性硅胶与树脂合成存在着难度,目前在这个领域的使用和推广已经成为可能。
同时也使用于有机-无机复合材料以及固化剂之中。


※粒径测定使用BET法。※以上数据为代表值非规格值
※如果您有需要定制的规格(如溶剂和表面修饰等),请及时与我们联系。


※粒径测定使用BET法。※以上数据为代表值非规格值。
※如果您有需要定制的规格(如溶剂和表面修饰等),请及时与我们联系。


※粒径测定使用BET法。※以上数据为代表值非规格值。
※如果您有需要定制的规格(如溶剂和表面修饰等),请及时与我们联系。